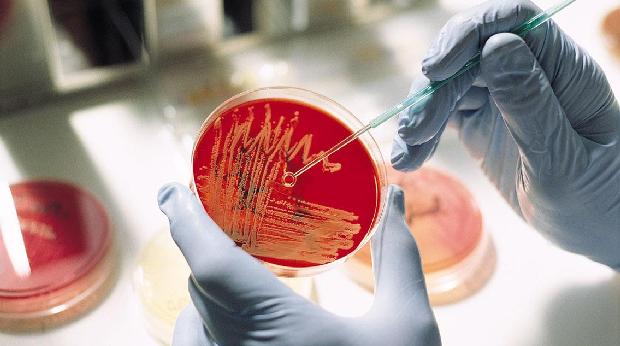
image

Уреаплазма (уреаплазмоз) — инфекционное заболевание, вызываемое микроорганизмами рода Ureaplasma, поражающее мочеполовую систему мужчин. Хотя многие случаи протекают бессимптомно, заболевание может вызвать серьезные осложнения, такие как воспалительные процессы и бесплодие. В статье рассмотрим основные симптомы уреаплазмоза у мужчин, а также методы диагностики и лечения, что поможет своевременно распознать проблему и обратиться за медицинской помощью.
Что такое уреаплазма и ее виды?
Установлено, что уреаплазма может обитать в микрофлоре влагалища или полового члена здорового человека в 60% случаев. У детей этот показатель составляет 30%. При этом носители микроорганизма зачастую не ощущают никакого дискомфорта. Основным защитным механизмом от активности этого патогенного микроба считается здоровая микрофлора слизистых половых органов и крепкий иммунитет. При ослаблении одного из этих факторов уреаплазма может активироваться, вызывая симптомы, схожие с различными заболеваниями половой системы. Основной причиной появления уреаплазмы в организме является незащищенный половой акт с инфицированным партнером.
Чтобы понять, что такое уреаплазма у мужчин и женщин, важно знать, что существует несколько видов этого микроорганизма. Наиболее распространенными являются:
- Уреаплазма парвум (ureaplasma parvum). Это наиболее опасный вид из группы уреаплазм. Данный тип бактерий не имеет собственной клеточной оболочки и, активируясь, проникает в клетки слизистой мочеполовой системы человека, что приводит к серьезным воспалительным процессам. Если говорить о том, что такое уреаплазмоз у мужчин, стоит отметить, что именно этот вид чаще всего встречается у представителей сильного пола.
- Уреаплазма уреалитикум. Этот вид микроба менее агрессивен и может долгое время не проявлять себя. Однако именно уреаплазма типа уреалитикум представляет наибольшую опасность для беременных женщин, так как это единственный тип уреаплазм, способный проникать через плаценту к плоду, что создает угрозу для здоровья малыша.
Важно: если женщина является носителем уреаплазмы уреалитикум, ей необходимо пройти лечение перед планированием беременности.
- Уреаплазма специес (ureaplasma species). Этот термин обозначает сочетание двух вышеупомянутых типов патогенных микроорганизмов. Если в слизистой пациента обнаружены оба этих вида, их называют уреаплазма специес. Следует отметить, что такой тип уреаплазмоза у мужчин может привести к снижению репродуктивной функции и даже бесплодию из-за разрушения структуры активных сперматозоидов.
Врачи подчеркивают, что при проведении лабораторных исследований важнее не только тип обнаруженного микроорганизма, но и его количество и активность.
Эксперты в области урологии и инфекционных заболеваний подчеркивают, что уреаплазмоз у мужчин часто протекает бессимптомно, что затрудняет его диагностику. Однако при наличии симптомов, таких как жжение при мочеиспускании, выделения из уретры и боли в области половых органов, важно обратиться к врачу. Специалисты рекомендуют проводить диагностику с помощью ПЦР-тестов, которые позволяют точно определить наличие уреаплазмы. Лечение обычно включает антибиотики, но выбор препарата зависит от чувствительности микроорганизма. Эксперты также акцентируют внимание на необходимости обследования половых партнеров и соблюдения мер предосторожности, чтобы предотвратить повторное заражение. Регулярные медицинские осмотры и внимание к своему здоровью помогут избежать осложнений, связанных с уреаплазмозом.

Общие сведения
Уреаплазмоз – бактериальная инфекция с преимущественным поражением репродуктивных и мочеиспускательных путей. Впервые симптомы были описаны как причина мужского бесплодия в 1967 году. Распространенность уреаплазмоза в группе негонококковых уретритов приближается к 16%. Частота выделения возбудителей из спермы и семявыводящих путей среди бесплодных мужчин составляет 5-58%, у фертильных лиц мужского пола 3-31%. Считается, что уреаплазмоз повышает вероятность заражения ВИЧ; вероятна роль бактерий в усугублении иммунодефицита и прогрессирования ВИЧ-инфекции до стадии СПИДа.
| Категория | Симптомы | Лечение |
|---|---|---|
| Общие симптомы | Отсутствие явных симптомов (часто бессимптомное течение) | Антибиотики (макролиды, тетрациклины, фторхинолоны) |
| Симптомы уретрита | Жжение и боль при мочеиспускании | Иммуномодуляторы (по показаниям) |
| Частые позывы к мочеиспусканию | Пробиотики (для восстановления микрофлоры) | |
| Выделения из уретры (прозрачные, слизистые или гнойные) | Местное лечение (инстилляции, ванночки) | |
| Симптомы простатита | Боли в промежности, мошонке, паху | Физиотерапия (массаж простаты, магнитотерапия) |
| Нарушение эрекции | Изменение образа жизни (отказ от алкоголя, курения) | |
| Преждевременная эякуляция | ||
| Симптомы эпидидимита/орхита | Боль и отек яичка/придатка яичка | |
| Повышение температуры тела | ||
| Осложнения (при отсутствии лечения) | Бесплодие | |
| Хронический простатит | ||
| Эпидидимит, орхит | ||
| Стриктура уретры |
Интересные факты
Вот несколько интересных фактов о уреаплазме и уреаплазмозе у мужчин:
-
Частота распространения: Уреаплазма является одним из самых распространенных патогенов, передающихся половым путем. Исследования показывают, что уреаплазма может быть обнаружена у 50-80% сексуально активных мужчин, однако не у всех развиваются симптомы или заболевания.
-
Симптомы и их разнообразие: Уреаплазмоз у мужчин может проявляться различными симптомами, включая жжение при мочеиспускании, выделения из уретры и боли в области половых органов. Однако у многих мужчин инфекция может протекать бессимптомно, что затрудняет диагностику и лечение.
-
Лечение и резистентность: Уреаплазмоз обычно лечится антибиотиками, такими как доксициклин или азитромицин. Однако существует проблема резистентности к антибиотикам, что делает лечение сложнее. Поэтому важно проводить диагностику и назначать лечение только после консультации с врачом, чтобы избежать неэффективного лечения и развития осложнений.

Действие уреаплазмы на заражённый организм
Уреаплазма относится к условно-патогенным микроорганизмам. Это означает, что она может быть обнаружена у здоровых людей. Данный микроорганизм может находиться в микрофлоре человека длительное время, не вызывая при этом никаких неприятных ощущений. Появление уреаплазмы в организме не всегда приводит к воспалительным процессам или заболеваниям. Нормальная микрофлора препятствует активному размножению уреаплазмы. Однако, если баланс микрофлоры нарушается, например, из-за снижения иммунной защиты при таких состояниях, как цистит, простатит, кольпит и другие воспалительные заболевания мочеполовой системы у мужчин и женщин, уреаплазма может активироваться, что приводит к патогенным изменениям. В настоящее время в медицинских документах не существует официального термина «уреаплазмоз» как отдельного инфекционного заболевания, однако могут упоминаться воспалительные процессы с указанием их локализации и уточнением, что они вызваны определённым видом уреаплазмы. Согласно последней классификации инфекций, передающихся половым путём, утверждённой Всемирной организацией здравоохранения в 2006 году, Ureaplasma urealyticum также включена в список возбудителей половых инфекций. Мы будем условно обозначать все патологические процессы, возникающие в результате активности уреаплазмы, как уреаплазмоз.
Характеристика инфекции
Уреаплазмоз у мужчин вызывают особые возбудители из группы микоплазм — уреаплазмы. Они выделены в отдельную группу Ureaplasma spp из-за своей уникальной биохимической активности — способности разлагать мочевину (с латинского языка «urea» переводится как «мочевина»). Сюда микробиологи отнесли следующие виды микроорганизмов:
- Ureaplasma urealyticum (уреаплазма уреалитикум);
- Ureaplasma parvum (уреаплазма парвум).
Уреаплазма — маленький микроорганизм, который имеет достаточно простое строение. На протяжении пятидесяти лет прошлого столетия между учеными происходили споры, что такое уреаплазма — бактерия или вирус. Она имеет схожие черты с этими двумя патогенами и представляет собой круглую или овальную клетку без клеточной стенки. Внутри клетки расположена генетическая информация в виде кольцевых молекул ДНК и небольшого количества РНК. В природе существует более 15 различных серотипов патогенных уреаплазм, незначительно отличающихся друг от друга по строению и свойствам.
Особенностью уреаплазмы является то, что она обитает практически у всех людей в мочеполовых путях, особенно в мочеиспускательном канале
Особенностью уреаплазмы является то, что она обитает практически у всех людей в мочеполовых путях, особенно в мочеиспускательном канале. На слизистых оболочках происходит рост и размножение микроорганизма, но это не приводит к заболеванию. Многие врачи считают, что уреаплазма уреалитикум и парвум у мужчин не являются возбудителями болезни, так как их абсолютная патогенность и враждебность по отношению к человеку не доказана. В исключительных случаях начинается усиленная колонизация урогенитального тракта, затем возникает инфекционный процесс.

Особенности уреаплазмы
Существует три типа возбудителей. Для человека представляют опасность только уреаплазма парвум (parvum) и уреаплазма уреалитикум, которые объединяются в подгруппу микроорганизмов, известную как уреаплазма специес. Клинические проявления этих инфекций схожи. Место обитания этих микроорганизмов – слизистые оболочки мочеполовой системы, где для них созданы наиболее благоприятные условия. Часто инфекция может сочетаться с другими заболеваниями, передающимися половым путем, такими как трихомониаз или хламидиоз.
Врач-иммунолог Ермаков Геннадий Александрович объясняет, что вызывает уреаплазмоз:
Какова разница между уреаплазмой парвум и уреалитикум? В случае с первой бактерией, она считается условно патогенной и обычно не проявляет себя. Мужчинам не требуется специального лечения. Уреалитикум, в свою очередь, требует обязательного лечения.
Подобно вирусам, уреаплазма не имеет ядра и внешней оболочки. Однако для ее терапии применяются антибиотики, которые не действуют на вирусы.
Уреаплазма и микоплазма имеют схожую структуру. Поэтому заболевания, такие как уреаплазмоз и микоплазмоз, часто проявляются одинаково. Чтобы избежать ошибок при назначении лечения, врач проведет комплексное обследование, которое поможет определить конкретного возбудителя.
Бактерии микоплазма и уреаплазма под микроскопом
Уреаплазма передается половым путем. Ранее считалось, что заразиться ею можно только через незащищенный классический секс. Однако сегодня многие специалисты считают, что инфекция может попасть в организм и при оральном сексе. Поэтому, если уреаплазма была выявлена, обследование и лечение необходимо пройти и половому партнеру, чтобы исключить риск повторного заражения.
Распространенность уреаплазмоза
Согласно статистике уреаплазма выявляется у 40-80% женщин, не предъявляющих жалоб на симптомы заболевания. Показатель зараженности инфекцией у мужчин несколько ниже.
Однако носительство Ureaplasma urealyticum очень часто у представителей сильной половины человечества не определяется лабораторной диагностикой.
Подтверждают это обследования семейных пар, в которых уреаплазмоз выявляется преимущественно у женщин.
Лечение пациенток позволяет добиться полного уничтожения микроорганизма. Но спустя некоторое время он обнаруживается вновь, что может указывать на то, что инфекция присутствует в организме постоянного партнера.
Поэтому при обследовании мужчин нужно тщательно выявлять все хронические очаги заболевания и использовать современные методы диагностики.
Чем опасна для мужчин и что будет, если не лечить
Опасность уреаплазмоза заключается как в его острой форме, так и в длительном бессимптомном носительстве. Последствия заболевания зависят от состояния иммунной системы и своевременности медицинского вмешательства. При острых формах неправильное лечение может привести к серьезным гнойным осложнениям в мочеполовом тракте. Если не принимать меры, инфекция может распространиться на верхние отделы урогенитального тракта, что приводит к острому циститу, а затем и к пиелонефриту — воспалению почек. Острый уреаплазменный пиелонефрит часто переходит в хроническую форму, которая сопровождается значительными нарушениями функции почек.
Близкое анатомическое расположение органов малого таза способствует быстрому распространению инфекций и развитию связанных заболеваний. Например, уретрит может привести к острому простатиту. Этот воспалительный процесс может вызвать образование абсцессов в предстательной железе, и гной может проникнуть в жировую клетчатку малого таза. Данное состояние представляет собой серьезную угрозу, так как может привести к сепсису или инфекционно-токсическому шоку. К счастью, такие осложнения встречаются довольно редко (менее 1%).
Длительное течение инфекции может привести к хроническому простатиту, что, в свою очередь, вызывает проблемы с эректильной функцией и нарушениями мочеиспускания. Если инфекция распространяется на яички и их придатки, это может привести к эпидидимоорхиту, что, в конечном итоге, может стать причиной мужского бесплодия. Если у пары долго не получается зачать ребенка, возможно, у мужчины сохраняется уреаплазма в мочеполовой системе.
В некоторых случаях возможно спонтанное выздоровление после острого заболевания без каких-либо последствий. Однако это не должно вводить пациентов в заблуждение. Уреаплазмоз требует лечения, чтобы избежать потенциальных осложнений. Необходимо незамедлительно обратиться к врачу, который проведет диагностику и определит оптимальный план лечения.
Виды бактерии уреаплазмы
Род Уреаплазма делится на 7 видов. Из этих 7 видов только 2 вызывают заболевание уреаплазмозом. Именно на наличие этих двух видов обычно берут лабораторные анализы:
- Уреаплазма уреалитикум (Ureaplasma urealyticum),
- Уреаплазма парвум (Ureaplasma parvum).
Когда в мазке обнаруживаются микроорганизмы обоих видов, их условно относят к Уреаплазма специес (Ureaplasma spp).
Определение вида микробов в первую очередь необходимо для назначения эффективной терапии. Что касается симптоматики заражения, она мало отличается, и по поводу специфики патогенности обоих микробов до сих пор ведутся споры. Но в целом исследователи склоняются к мнению, что особой разницы в подходе к лечению заболеваний, вызываемых этими двумя микроорганизмами, нет. И схема лечения во всех случаях уреаплазмоза будет одинаковой (антибиотики + местное лечение + иммуностимулирующая терапия).
Немного о микроорганизме
Уреаплазма представляет собой уникальный микроорганизм, который относится к группе микоплазм. Его особенность заключается в отсутствии собственной клеточной стенки, что делает его мембранным паразитом. Некоторые ученые считают, что микоплазмы, включая уреаплазму, являются одними из самых простых микроорганизмов, способных к самостоятельному размножению.
На первый взгляд может показаться, что проблемы с беременностью не касаются мужчин, ведь ни один представитель сильного пола не может забеременеть. Тем не менее, каждый ответственный мужчина заботится о здоровье своей партнерши и будущем своих детей.
Согласно данным ряда исследователей, примерно 60-70% женщин по всему миру являются носителями уреаплазмы. Это создает повышенный риск заражения для мужчин, особенно если их иммунная система не в лучшем состоянии.
Причины уреаплазмоза у мужчин
Как заражаются
Заражение может произойти через незащищенные половые контакты. Чаще всего носителем инфекции оказывается женщина. При попадании в организм мужчины, инфекция негативно сказывается на его половой функции и может даже находиться на поверхности сперматозоидов. Проникновение бактерий внутрь организма может привести к поражению мочевыделительной системы, матки, мочеточников и почек.
Инфекция может передаваться от матери к ребенку. Внутриутробное заражение происходит через плацентарный барьер, после чего микроб проникает через желудочно-кишечный тракт, кожу, оболочку глаз и мочеполовую систему новорожденного.
- При родах ребенок может заразиться через родовые пути матери;
- Трансплантация органов, особенно в экстренных случаях, также может стать источником инфекции;
- Реже, но возможно заражение при оральных ласках и анальном контакте.
При взаимодействии с инфицированным человеком возбудитель передается воздушно-капельным или бытовым путем лишь в 0,9-1,0% всех случаев заболеваний.
Источники заражения
Уреаплазмоз у мужчин имеет три причины возникновения:
- половое распространение;
- контактно-бытовая передача через предметы обихода;
- передача возбудителя от матери к плоду.
Уреаплазма парвум и уреалитикум у мужчин в 95% случаев появляются после незащищенного полового акта. Источником инфекции является больной урогенитальной формой уреаплазмоза. Путь передачи — половой. Возбудители передаются мужчине от зараженной женщины через вагинальный секрет, в котором их находится большое количество. Шанс заражения инфекцией при однократном незащищенном половом акте составляет более 60%, при повторном — около 90%. Большему риску подвергается партнер с ослабленной иммунной системой и плохой резистентностью к любым инфекциям. У таких людей чаще наблюдается развитие острого уретрита с яркой клинической картиной. Уреаплазма парвум и уреалитикум у мужчин в 95% случаев появляются после незащищенного полового акта
Гораздо реже бывает инфицирование контактно-бытовым путём. Уреаплазма может некоторое время выживать на различных предметах, вещах и поверхностях, откуда затем попадает в организм человека. Наибольшая контаминация характерна для средств личной гигиены, полотенец, помещений туалета и ванны. Опасность представляют также общественные бани и сауны. Многие забывают о посещении этих мест и не понимают, откуда у них берется уреаплазма в организме. До появления симптомов болезни может пройти длительный срок, а заражённый человек сам становится источником инфекции.
Заражение уреаплазмами возможно и в утробе через плаценту от матери к плоду (вертикальный или трансплацентарный пусть передачи). При прохождении ребенка по половым путям во время родов бывает инфицирование ребенка двумя способами. Ребенок, находясь во влагалище, аспирирует содержимое инфицированных путей, что провоцирует развитие бронхопневмонии, требующей длительного лечения. Контактно у девочек может возникнуть вульвовагинит, у мальчиков уретрит или баланопостит.
Проявления уреаплазмоза у мужчин
Уреаплазма у мужчин может долго оставаться незамеченной. Бактерии активно размножаются и осваивают новые участки организма. Инфицированный мужчина, не подозревая о наличии инфекции, может передать ее своим половым партнерам.
При снижении иммунной защиты и увеличении числа бактерий начинают проявляться признаки воспалительных процессов в мочеполовой системе. К основным симптомам уреаплазмы у мужчин относятся:
- Частое и скудное мочеиспускание.
- Ощущение жжения и боли во время мочеиспускания.
- Боль в нижней части живота или в области паха.
- Выделения из полового члена.
- Повышенная температура.
- Общая слабость и усталость.
В некоторых случаях у мужчины могут возникнуть симптомы интоксикации, такие как тошнота, рвота и диарея. Эти проявления указывают на серьезное бактериальное поражение органов мочеполовой системы, и симптомы уреаплазмы парвум у мужчин не остаются без внимания. Часто уреаплазмоз сопровождается другими инфекциями, передающимися половым путем, такими как хламидиоз, микоплазмоз, трихомониаз и гонококковая инфекция.
Особенности протекания патологии у мужчин
Уреаплазмоз у мужчин специфической симптоматикой не характеризуется, основные проявления болезни сходны с воспалительными процессами, это:
- Появление необычных прозрачных выделений;
- Боль и жжение во время мочеиспускания. Сильные рези характеры для запущенных стадий инфекции;
- Зуд по ходу уретры;
- Нарушение эрекции.
Отсутствие лечения становится причиной поражения уреаплазмой предстательной железы, возникает простатит. При этом появляются характерные симптомы:
- Повышение температуры, что связано с интоксикацией организма;
- Сильные боли в паху и промежности;
- Нарушение мочеиспускания. Отечная предстательная железа давит на мочеиспускательный канал, просвет уретры сужается, что приводит к затрудненному мочеиспусканию и к возникновению никтурии – состояния, при котором учащаются позывы к выделению мочи в ночные часы;
- Гнойные выделения. Указывают на активный воспалительный процесс.
Уреаплазмы по восходящим путям нередко поднимаются выше, вызывая цистит и пиелонефрит.
Мужчины к врачам чаще всего обращаются уже на стадии появления признаков простатита и воспаления почек и мочевого пузыря, поэтому лечение может быть длительным.
Инкубационный период при уреаплазмозе у мужчин
Заражение происходит через половой контакт, при этом первыми страдает уретра.
Уреаплазмы прикрепляются к слизистой оболочке уретры и начинают её колонизировать.
Существует несколько возможных исходов данного заболевания.
Первый – уреаплазмоносительство.
У мужчин уреаплазмы будут находиться в урогенитальном тракте, но при этом воспалительные симптомы не проявятся.
Второй вариант – самопроизвольное выздоровление.
Уреаплазмы могут исчезнуть самостоятельно спустя некоторое время.
Третий – развитие уретрита.
При этом наблюдается увеличение числа уреаплазм, что приводит к началу воспалительных процессов.
Инкубационный период данного заболевания в среднем составляет около одного месяца.
Степень риска воспаления зависит от количества уреаплазм.
Исследования показывают, что у мужчин симптомы уретрита возникают в 11% случаев, если уреаплазмы обнаруживаются в количестве 10 в 4 степени КОЕ/мл и более.
Если же концентрация этих бактерий составляет 10 в 3 степени и меньше, риск активного воспалительного процесса в уретре снижается до 3%.
Таким образом, большую часть времени симптомы этой инфекции отсутствуют.
Они начинают проявляться при увеличении численности уреаплазм.
Это может происходить под воздействием следующих факторов:
- заражение другими инфекциями, передающимися половым путем;
- ослабление иммунной системы;
- наличие сахарного диабета;
- травмы уретры;
- переохлаждение и другие причины.
Возможные осложнения инфекции у мужчин
Нелеченая острая форма уреаплазмы переходит в хроническую, при этом риск развития нижеописанных осложнений достаточно высок:
- Уретрит – воспаление мочеиспускательного канала. На его развитие указывают усиливающиеся рези и боли при мочеиспускании, жжение, зуд;
- Стриктура уретры – сращение стенок канала друг с другом. Сращение не является полным, поэтому мочеиспускание возможно, но добиться выделения мочи можно, только приложив немало усилий;
- Эпидидимита – воспаления придатка (семенника) яичек. Заболевание не приводит к болям, но воспаленный придаток в области мошонки становится плотным, увеличивается в размерах;
- Астеноспермия – снижение подвижности сперматозоидов, возникающее вследствие паразитирования уреаплазм. Астеноспермия является одной из форм мужского бесплодия;
- Воспаление суставов. Уреаплазменные артриты возникают исключительно редко, но вылечить их трудно.
Симптомы хронического уреаплазмоза у мужчин
| 1 | Хронический уреаплазменный уретрит |
| 2 | Хронический уреаплазменный простатит |
| 3 | Хронический уреаплазменный везикулит (воспаление семенных пузырьков) |
| 4 | Хронический эпидидимит или орхо-эпидидимит (воспаление придатка яичка и самого яичка) |
| 5 | Хронический цистит |
| 6 | Хронический проктит – воспаление прямой кишки |
| 7 | Хронический фарингит – воспаление глотки |
Два последних заболевания встречаются довольно редко. Чаще всего мужчины обращаются за медицинской помощью при хроническом уреаплазмозе на стадии простатита или при поражении органов мошонки.
Диагностика уреаплазмоза у мужчин осуществляется с использованием комплексного подхода, включающего лабораторные и инструментальные методы.
Для выявления патогенных микроорганизмов Ureaplasma urealyticum и Ureaplasma parvum применяются различные анализы на уреаплазмоз. Ультразвуковое исследование, магнитно-резонансная томография и компьютерная томография используются для оценки степени поражения внутренних половых органов мужчин, выявления увеличения их размеров, а также наличия рубцов, камней и кист.
Уреаплазма у мужчин: к какому доктору идти за помощью
Часто звучит вопрос о том, какой врач будет помогать мужчине, у которого возникли проблемы, спровоцированные уреаплазмозом.
Существует несколько вариантов.
Во-первых, всегда стоит посетить венеролога.
Этот доктор занимается ИППП, и патогенный микроорганизм находится в его юрисдикции.
Венеролог же будет оказывать помощь при поражении бактерией области ануса.
Порой он может делать это совместно с проктологом.
Также за помощью можно обратиться к урологу.
Доктор не специализируется на инфекциях, но может оказать медицинскую помощь при уреаплазмозе, если есть необходимость.
Если же поражено горло или дыхательные пути, лучшим выходом будет посещение ЛОРа.
Как ставят диагноз
Для диагностики уреаплазмоза необходимо пройти ряд анализов:
- соскоб из уретры (исследуется с использованием метода ПЦР);
- анализ крови (проводится иммуноферментным методом и с применением реакции непрямой иммунофлюоресценции);
- посев на антибиотикорезистентность;
- спермограмма.
Метод полимеразной цепной реакции (ПЦР) заключается в анализе ДНК патогенных микроорганизмов в биологическом материале. ПЦР позволяет выявить наличие и тип уреаплазмы в образце. Это один из самых надежных методов диагностики. Однако стоит отметить, что ПЦР не позволяет оценить численность уреаплазма парвум у мужчин.
Анализ крови чаще всего выполняется с использованием метода ИФА. Иммуноферментный анализ предназначен для выявления специфических антител и антигенов в биологической жидкости. С помощью ИФА можно точно определить вид возбудителя, его численность и стадию заболевания.
Реакция непрямой иммунофлюоресценции (РНИФ) позволяет обнаружить комплексы антиген-антитело в образце крови. Для этого материал обрабатывают специальной сывороткой, содержащей флуоресцентные метки. Затем образец исследуется под люминесцентным микроскопом, что дает возможность определить вид и численность бактерий.
Методы ИФА и РНИФ обладают высокой чувствительностью и способны выявлять антигены даже в минимальных концентрациях. Анализ крови также может проводиться с использованием метода ПЦР.
Методы диагностики
Уреаплазма парвум у мужчин не всегда приводит к появлению заболеваний. В медицинской практике часто встречаются случаи присутствия бактерий-возбудителей в организме здоровых мужчин.
Диагноз уреаплазмоз ставится, лишь если количество микроорганизмов превышает допустимую норму. Самый надежный способ выявления уреаплазмоза – метод ПЦР. Любой мужчина, имеющий причины подозревать наличие заболевания, может сдать такой анализ и получить достоверный ответ.
Принципы диагностики уреаплазмы
Диагностика уреаплазмоза у мужчин, как правило, не вызывает особых трудностей.
Если речь идет о типичной урогенитальной форме заболевания, для установления диагноза необходимо сдать мазок из уретры.
Хотя эта процедура может быть неприятной, она является важной.
Она предоставляет максимальное количество информации для диагностики, что в конечном итоге позволяет правильно определить заболевание.
Мазок из уретры может быть проанализирован с использованием различных методов диагностики.
Наиболее распространенными являются посев и иммуноферментный анализ (ИФА), однако также может быть использован и метод полимеразной цепной реакции (ПЦР), хотя он и стоит дороже.
Интерпретация результатов анализа на уреаплазму у мужчин должна проводиться квалифицированным врачом.
Специалист сможет оценить степень запущенности заболевания и решить, требуется ли лечение.
В качестве менее неприятной альтернативы забору мазка для исследования можно использовать ПЦР анализа мочи, спермы или секрета простаты.
Также возможен анализ крови, в котором определяются антитела классов A, M и G, а также их соотношение для точной постановки диагноза.
Где сдается материал на уреаплазмоз
Сдать биоматериал на обнаружение уреаплазмы в настоящее время возможно практически в любой муниципальной и частной клинике.
Точность диагностики зависит не только от метода исследования, но и от используемого в выбранной лаборатории оборудования.
Поэтому лучше диагностику проводит в современных медцентрах, специализирующихся именно на лабораторной диагностике.
Правила забора биоматериала
Точность лабораторных методов диагностики уреаплазмоза во многом зависит от правильности сбора биоматериала:
- Кровь для анализа рекомендуется сдавать утром натощак;
- Для анализа мочи желательно не мочиться как минимум 5 часов, поэтому лучше использовать утреннюю порцию;
- При заборе соскоба из уретры мужчины должны воздерживаться от мочеиспускания минимум 2 часа;
- Женщинам не следует брать мазок из влагалища и соскоб во время менструации, оптимально проводить забор в середине менструального цикла;
- Рекомендуется избегать половых контактов за 2-3 дня до сбора биоматериала из уретры и половых органов;
- Перед сдачей соскоба и мазка интимную гигиену следует провести вечером накануне анализа, утром этого делать нельзя;
- Женщинам за несколько дней до забора биоматериала стоит отказаться от использования местных контрацептивов, таких как мази, свечи и вагинальные таблетки, а также не проводить спринцевания и не подмываться горячей водой.
Ложноотрицательные результаты могут возникнуть, если менее чем за месяц до анализа пациент принимал противовирусные или антибактериальные препараты. Поэтому важно информировать врача о подобном лечении.
Мазки при уреаплазме у мужчин
По одним только симптомам уреаплазмоз у мужчин не диагностируют.
Требуются анализы, подтверждающие диагноз.
Обследование проводится на все половые инфекции.
Потому что уреаплазмоз – диагноз исключения.
Он редко вызывает симптомы.
Если мужчина обратился с жалобами на выделения, покраснение, отек уретры и т.д., что врач скорее подумает о других инфекциях, а не об уреаплазмозе.
Поэтому он возьмет мазки на трихомониаз, гонорею, хламидиоз, герпес.
Одновременно выполняется и диагностика уреаплазмоза.
Если эта инфекция есть, а других возбудителей нет, выставляется соответствующий диагноз.
ПЦР
Метод полимеразной цепной реакции (ПЦР) основывается на многократном дублировании участков РНК и ДНК бактерий, найденных в биологическом материале, таком как мазок из уретры. Если уровень РНК уреаплазмы составляет менее 10 в 4 степени, то бактерия не считается активной, и, соответственно, заболевание отсутствует. Более высокий уровень указывает на необходимость проведения антибактериальной терапии.
Посев при уреаплазмозе у мужчин
Уреаплазмы растут на питательных средах.
Они культивируются в течение 4-5 дней.
Идентифицируются по внешнему виду культур и способности расщеплять мочевину.
Благодаря посеву врач может установить восприимчивость бактерий к антибиотикам.
Метод имеет преимущества и недостатки.
Недостатки состоят в следующем:
- более высокая цена, чем у ПЦР;
- дольше нужно ждать результатов;
- меньшая чувствительность теста (чаще выдаются ложноотрицательные результаты).
Есть и преимущества.
Методика обладает более высокой специфичностью.
Но главное – посев позволяет оценить чувствительность к разным антибиотикам. Это значительно повышает результативность лечения.
В среднем при назначении терапии эмпирически (без оценки чувствительности) излечение после первого курса подтверждается приблизительно в 65% случаев.
Если же перед этим был проведен посев, то эффективность терапии возрастает до 92%.
Анализ крови на антитела при уреаплазмозе
Анализ крови является важным вспомогательным методом исследования.
Однако он не может служить окончательным подтверждением диагноза или свидетельством о выздоровлении.
Это связано с тем, что данный тест чаще других методов может давать как ложноположительные, так и ложноотрицательные результаты.
Тем не менее, у анализа крови есть свои положительные стороны.
Тест на антитела позволяет определить стадию инфекции.
Он помогает выяснить, когда именно произошло заражение, а также как протекает уреаплазмоз у мужчин.
В процессе диагностики в крови выявляется несколько классов иммуноглобулинов.
IgG начинают обнаруживаться в крови на постоянной основе и остаются там до полного выздоровления, а также еще на протяжении нескольких месяцев после.
Обнаружение IgM в крови указывает на недавнее заражение.
Если в анализе присутствуют только IgG, это свидетельствует о хронической инфекции.
ИФА (иммуноферментный анализ) крови
Исследование выявляет наличие в крови антител к чужеродным антигенам. В данном случае, к уреаплазме. Заранее очищенный антиген помещается на исследовательскую поверхность, и к нему добавляется кровь пациента. При реакции антител и антигенов формируются иммунные комплексы – показатели наличия инфекции. Если уреаплазма в крови отсутствует, комплекс не образуется.
Кровь на ИФА необходимо сдавать исключительно натощак.
В случае обнаружения большого количества уреплазмы, в мазке или крови проводится антибиотикограмма — определение на резистентность бактерий к антибиотикам.
Сроки сдачи анализов после лечения уреаплазмоза у мужчин
После завершения лечения уреаплазмоза и микоплазмоза у мужчин необходимо провести контрольные исследования.
Контроль осуществляется с помощью метода ПЦР.
Также может быть применен бактериальный посев.
Для повышения точности результатов рекомендуется дополнительно сдать анализы крови на наличие антител.
Однако эти анализы служат лишь вспомогательными по отношению к прямым методам выявления уреаплазм.
Исследования назначаются через месяц после завершения терапии.
Если результаты анализов отрицательные и отсутствуют симптомы, это свидетельствует о том, что мужчина здоров.
В случае положительных результатов потребуется повторный курс лечения.
Он будет проводиться с использованием других препаратов.
Врач может рекомендовать бактериальный посев с определением чувствительности к антибиотикам для более точного подбора схемы лечения.
Расшифровка анализов
Расшифровка проводится специалистом. Для каждого метода исследования имеется своя норма. При обследовании по методу ИФА в бланке обозначается количество антител (титр) и рядом стоят показатели нормы.
В разных лабораториях используется свое оборудование, поэтому и нормальный титр может быть разным.
При проведении ПЦР и культурального метода нормой считается 104 КОЕ на 1 мл пробы, превышение этого значения указывает на патологию. Но в любом случае анализы должен расшифровывать лечащий врач и уже на их основании подбирать схему лечения.
Обнаружена уреаплазма, что делать?
При выявлении уреаплазмы в анамнезе не всегда необходимо немедленно приступать к лечению. Некоторые специалисты считают этот микроорганизм условно-патогенным. Эти микробы могут вызывать заболевания только при ослаблении иммунной системы.
Когда защитные функции организма находятся на должном уровне, инфекции, как правило, не развиваются. Однако не все врачи придерживаются такого мнения относительно уреаплазменной инфекции. Многие специалисты убеждены, что уреаплазма не является частью нормальной микрофлоры человека. Они склонны начинать терапию у мужчин сразу после выявления этого микроорганизма. Важно также учитывать титр микробов: если их количество невелико, можно использовать антибактериальные препараты. В случае высокого титра возбудителей необходим тщательный медицинский осмотр.
Схема лечения уреаплазмы у мужчин
Лечение уреаплазмы у мужчин представляет собой сложный и серьезный процесс. В схему лечения входят антибактериальные препараты, иммуномодуляторы, восстанавливающая терапия, биостимуляторы, противогрибковые препараты, гигиена половых органов, поливитаминные комплексы, соблюдение диеты. Схема лечения составляется исключительно вашим лечащим врачом. Лечение длится примерно 10-14 дней.
Схема лечения:
- Антибиотики:
- макролиды (считаются наиболее эффективными) – эритромицин (зинерит), джозамицин (вильпрафен), азитрмоицин (сумамед), клатромицин (клацид, калабакс), ровамицин, мидекамицин (макропен);
- фторхинолоны (препапарты второго ряда) – ципрофлоксацин (цифран); офлоксацин; левофлоксацин (леволет); пефлоксацин;
- тетрациклины – миноциклин, юнидокс-солютаб, вибрамицин;
- линкозамиды – далацин, клиндамицин;
- Аминогликозиды – гентамицин.
- Иммуномодулирующие средства:
- циклоферон;
- полиоксидоний;
- интерфероны (генферон, виферон);
- уреаплазма-иммун;
- иммуномакс;
- ликопид;
- галавит;
- тактивин;
- тималин.
- Восстановление кишечной флоры:
- Линекс;
- Бифиформ;
- Бактисубтил;
- Хилак-Форте;
- Бификол;
- Лактобактерин;
- Бифидобактерин;
- Восстановление печени
- гепатопротекторы – гепрал, карсил;
- галавит – иммуномодулирующий препарат, защищает печень.
- Биостимуляторы – плазмол, пантокрин,
- Противогрибковые препараты: обычно эти препараты назначают вместе с антибиотиками, чтобы избежать дисбактериоза кишечника и влагалища.
- фентиконазол – ломексин,
- бифоназол – бифосин,
- клотримазол – кагдид-Б,
- полиены – нистатин, леворин, пимофуцин,
- ороназол;
- кетоконазол (себозол);
- итраконазол (ирунин, орунгал, текназол, орунгал, орунит);
- флуконазол (флюкостат, дифлюкан, фунголон, дифлазон, микосист);
- Адаптогены – женьшень, родиола розовая, эхинацея пурпурная;
- Ферменты – вобэнзим, серта.
- Витамины – подойдут любые поливитаминные комплексы: пиковит, компливит, центрум, алфавит, витрум, милайф, биомакс; витамин С, витамины группы В;
- Свечи – так же используются при лечении;
- Гигиена половых органов – промывание полового члена хлоргексидином;
- Физиотерапевтические процедуры – МЛТ (магнитно – лазерная терапия);
В чем состоит лечебная тактика при уреаплазме у мужчин?
Лечебная стратегия может включать в себя следующие мероприятия:
- Антибиотикотерапия;
- Профилактика дисбактериоза;
- Иммунокоррекция;
- Щадящая диета;
- Общие физиотерапевтические процедуры.
Этиотропное лечение пациентов с уреаплазмозом осуществляется в зависимости от стадии воспалительного процесса, вызванного уреаплазмой.
Антибиотикотерапия назначается с учетом чувствительности и реакции организма на антибиотики. В основном используются препараты тетрациклиновой группы:
- Тетрациклин принимается внутрь по 500 мг 4 раза в день,
- Доксациклин (“ЮнидоксСалютаб”) — по 100 мг 2 раза в день.
Если уреаплазма проявляет устойчивость к этим антибиотикам, их можно заменить на фторхинолоны или макролиды.
- Эритромицин — по 500 мг 4 раза в день в течение 10-14 дней;
- Азитромицин — 1 г (4 капсулы) в первый день, затем по 500 мг один раз в день на протяжении 4 дней.
Иногда целесообразно одновременно назначать антибактериальные препараты из разных групп.
Курс лечения уреаплазмы у мужчин составляет 8-10 дней. Важно помнить, что если пациент ранее проходил курс лечения, но не завершил его, для терапии вновь возникшей инфекции следует использовать другие медикаменты, так как уреаплазма могла адаптироваться к ранее применяемым препаратам.
Во время лечения необходимо полностью исключить половую близость. Использование презерватива не гарантирует защиту от уреаплазмы.
Лечение
На первичном приеме врач выслушает жалобы пациента, соберет анамнез, проведет осмотр, назначит необходимые исследования. Комплект анализов зависит от конкретного случая. В клиниках НИАРМЕДИК исследования проводятся быстро и в полном объеме.
После получения анализов и выявления причин наблюдаемой клинической картины, а также сопутствующих заболеваний и инфекций врач, составляет схему лечения, включающую медицинские препараты и терапию. Если признаки заболевания отсутствуют, а уреаплазмы в анализах есть, врач может начать лечить пациента превентивно.
Подбор схемы лечения производится индивидуально и может включать:
- антибиотики;
- противогрибковые и противопротозойные препараты;
- иммуномодуляторы;
- витамины;
- местное лечение;
- физиотерапию.
Если пациент ранее уже лечился от этой инфекции, доктору важно знать прошлую схему лечения, чтобы скорректировать ее и заменить активные препараты, не давшие результатов. У уреаплазмы отсутствует клеточная стенка, поэтому она быстро вырабатывает устойчивость к антибиотикам, направленным на разрушение этой стенки. Антибиотики тетрациклинового ряда, например, Доксициклин, не являются эффективными, поскольку сегодняшние штаммы микроорганизма устойчивы к нему. Чаще всего в схему включаются макролиды и хинолоны.
Среди макролидов часто используют:
- Эритромицин – активнее чем сумамед, принимается курсом на 10 или 7 дней;
- Ровамицин – накапливается в очаге воспаления, курс составляет 10 дней;
- Рокситромицин – принимается 2 недели;
- Кларитромицин – может приниматься перорально и внутривенно (в сложных случаях) и т.д.
Общий средний курс лечения составляет 2 недели. В сложных случаях, особенно при сочетании с другими болезнями, курс лечения может быть более продолжительным. В процессе лечения исключается занятие сексом без барьерной контрацепции, алкоголь и часть пищевых продуктов. Через 2 недели после окончания курса проводится новое исследование для прояснения результатов лечения. Если ситуация не изменилась, разрабатывается новая схема. Если анализы указывают на эффективность лечения, врач выдает индивидуальный план посещений и контрольных исследований. Первое посещение планируется через 3-4 недели.
По окончании лечения при необходимости может быть назначен курс физиотерапии и восстановительных препаратов и процедур. К ним относятся:
- массаж простаты (если произошли осложнения и был поставлен диагноз «простатит»);
- иммуномодуляторы;
- препараты для восстановления микрофлоры кишечника при ее нарушении;
- лекарства для восстановления работоспособности желчного пузыря и печени;
- специальная диета – должна содержать молочнокислые и витаминизированные продукты и исключать острую, жирную, перченую, копченую пищу, спиртное, соусы.
Поскольку уреаплазмоз передается к мужчине как правило половым путем, диагностику рекомендуется пройти обоим партнерам, даже если у второго не наблюдается никаких проявлений (инфекция может протекать скрыто). Основной профилактической мерой во избежание повторного заражения являются барьерные средства контрацепции.
Схема лечения
Как проводится лечение уреаплазмы у мужчин и женщин? Процесс терапии уреаплазмоза у мужчин состоит из двух ключевых этапов. Первый этап направлен на уничтожение бактерий, а второй – на восстановление нормального функционирования организма. Лечение уреаплазмы у мужчин осуществляется с использованием следующих групп медикаментов:
- Антибиотики. В основном применяются тетрациклины. Если анализы показывают, что микроорганизмы устойчивы к этой группе препаратов, назначаются макролиды. В случаях, когда уреаплазмоз сочетается с другими инфекциями, используются фторхинолоны.
- Пробиотики. Применение антибиотиков может нарушить баланс микрофлоры кишечника, поэтому для предотвращения этого назначаются пробиотики.
- Антигистаминные средства. Антибиотики и токсины, выделяемые погибшими бактериями, могут вызывать сильные аллергические реакции. Антигистаминные препараты помогают блокировать действие гистамина, основного медиатора аллергии.
- Витаминные комплексы. Они способствуют нормализации работы регуляторной системы организма и обмена веществ.
- Иммуномодуляторы. Эти препараты помогают повысить уровень иммунной защиты.
Схема и продолжительность лечения уреаплазмы у мужчин зависят от степени тяжести заболевания и индивидуальных характеристик пациента. На время терапии рекомендуется воздержаться от половых контактов, курения, а также от употребления жирной и острой пищи. Если уреаплазмоз привел к простатиту, в период восстановления мужчине может быть назначен массаж простаты.
Контроль эффективности лечения уреаплазмы осуществляется с помощью клинических анализов. По завершении курса антибиотиков пациент должен сдать анализы крови и соскоб из мочеиспускательного канала. Если в образцах не обнаружены антигены, это свидетельствует о успешности проведенной терапии.
Антибиотики
Антибиотики при урогенительном уреаплазмозе у мужчин занимают ведущее место в лечении. Схема лечения назначается лечащим врачом на основании результатов антибиотикочувствительности микроорганизма. Если использовались методы ПЦР или серодиагностики, то назначают «стандартный» курс лечения, включающий комбинацию антибактериальных препаратов или один препарат широкого спектра действия.
Наиболее часто используемые препараты:
- бета-лактамные антибиотики группы пенициллинов — Амоксициллин или Амоксиклав;
- макролиды — Азитромицин, Эритромицин, Кларитромицин, Рокситромицин;
- тетрациклины — Доксициклин, реже Тетрациклин;
- цефалоспорины — Цефтриаксон, Цефотаксим, Цефтобипрол.
Для лечения наиболее часто используют группу макролидов и Доксициклин. У них меньше всего выражены отрицательные последствия, потому что токсичность лекарств для организма минимальна. Курс лечения антибиотиками зависит от препарата и составляет от 7 до 14 дней. Для мужчин с выраженной недостаточностью почечной или печеночной функции препараты назначаются в минимальной дозировке, а в терапию включают мази и крема с противомикробными лекарственными веществами. Иногда лечение уреаплазмы у мужчин дополняют противогрибковые препараты. Это необходимо для профилактики развития кандидоза слизистых оболочек.
Правила применения антибиотиков при уреаплазме
Сроки и эффективность лечебных схем во многом зависят от того, насколько строго пациент следует рекомендациям по приему основных препаратов.
При уреаплазмозе основными средствами являются антибиотики.
Эти препараты требуют особого внимания как со стороны врачей, так и со стороны пациентов.
Важно минимизировать количество побочных эффектов и получить максимальную пользу от применения этих медикаментов.
Рекомендуется придерживаться следующих простых правил:
- полностью отказаться от самоназначения, полагаясь исключительно на рекомендации врача
- не слушать советы друзей и знакомых по поводу приема антибиотиков, доверяя только мнению специалиста
- в идеале начинать лечение только после подтверждения чувствительности микроорганизма к выбранному препарату с помощью анализа посева (к сожалению, такая возможность не всегда доступна и зависит от оснащения медицинского учреждения)
- строго следовать назначенным врачом дозировкам, не снижая и не увеличивая их самостоятельно для ускорения эффекта
- ни в коем случае не прекращать лечение раньше установленного врачом срока, даже если кажется, что болезнь полностью устранена
Если схема лечения, предложенная врачом, будет строго соблюдаться на протяжении всего курса, вероятность успешного выздоровления значительно возрастает.
В противном случае, когда пациент самовольно назначает и отменяет препараты, шансы на успех снижаются.
Главное – вовремя распознать первые признаки уреаплазмы у мужчин и начать полноценное лечение под контролем квалифицированного специалиста.
Контрольные анализы по окончании терапии являются обязательной частью процесса лечения.
Без их результатов невозможно говорить о выздоровлении, о чем обязательно проинформирует врач.
Азитромицин
Несмотря на то, что этот медикамент является одним из самых безопасных средств, он эффективно борется с большинством видов бактерий. Несомненным достоинством этого средства является то, что оно устойчиво к кислой среде, способно растворяться в жирах и может проникать в глубинные ткани мочеполовой системы. Поскольку этот препарат довольно медленно выводится из организма, его рекомендуется пить один раз в день до приема пищи.
Если диагностика подтвердила, что заражение уреаплазмой произошло относительно недавно, специалист может назначить однократный прием таблеток Азитромицина (дозировка подбирается индивидуально для каждого человека). Если болезнь имеет хроническую форму, подобная схема лечения будет неэффективной, поскольку препарат лишь устранит симптоматику на несколько дней. В большинстве случаев Азитромицин нужно будет принимать около 10 дней, делая при этом перерыв. Найти более подробную инструкцию по дозировке препарата и схеме употребления можно в прилагаемой инструкции.
Так как этот медикамент является довольно действенным и может негативно сказаться на состоянии печени, то во время лечения этим средством трижды в день рекомендуется пить травяной сбор на основе Расторопши.
Доксициклин
В отличие от других аналогичных медикаментов, Доксициклин демонстрирует широкий спектр применения и практически не вызывает нежелательных эффектов. Этот препарат относится к полусинтетическим средствам и способен проникать внутрь различных микроорганизмов, нарушая процессы синтеза белка и некоторых ферментов. В результате такого воздействия бактерии теряют способность к размножению и становятся неактивными. Доксициклин оказывает мягкое воздействие на организм. Он быстро всасывается в желудочно-кишечном тракте и полностью выводится из организма в течение 20 часов после приема.
Как правильно использовать Доксициклин для лечения уреаплазмоза у мужчин? Эти таблетки следует принимать после еды, чтобы обеспечить их оптимальное усвоение организмом, запивая большим количеством воды. Дозировку препарата необходимо подбирать только лечащему врачу, а продолжительность курса лечения обычно составляет от 10 до 14 дней, в зависимости от реакции организма на терапию.
Кларитромицин
Это антибактериальное средство является производной Эритромицина и выпускается в виде таблеток. Поскольку таблетки очень хорошо усваиваются организмом, они полностью выводятся вместе с калом в течение следующих нескольких суток.
Медикамент устойчив к кислой среде и также способен проникать сквозь мембраны патогенных микроорганизмов. Кларитромицин обладает сильным противовоспалительным действием и способен понижать уровень окислительных процессов во время метаболизма в фагоцитах.
Суточная доза лекарства может варьироваться в зависимости от течения болезни. Курс лечения в большинстве случаев длится от 5 дней до 2 недель. На данный момент этот антибиотик является одним из наиболее эффективных методов борьбы с Уреаплазмозом.
Авелокс
Антибактериальный препарат нового поколения, содержащий в своем составе моксифлоксацин, широко используется в медицинской практике. Благодаря своему универсальному действию, врачи часто назначают его для лечения Уреаплазмоза.
Авелокс предназначен исключительно для перорального применения. Одним из его главных преимуществ является простота использования — таблетки можно принимать в любое время суток и независимо от приема пищи. Врачи рекомендуют принимать препарат целиком, без деления на части или рассасывания. Дозировку и продолжительность курса лечения должен определять лечащий врач, однако обычно терапия продолжается около 8—10 дней.
В редких случаях неправильное использование Авелокса может привести к возникновению некоторых побочных эффектов:
- ощущение тошноты и рвоты;
- дискомфорт и боли в животе;
- длительная диарея;
- общая слабость организма.
Макропен
Данный препарат относится к группе макролидов. Основным действующим веществом является – мидекамицин. Препарат Макропен быстро всасывается в ЖКТ. Он начинает действовать спустя 1–2 часа. Макропен выводится по большей части печенью.
Препарат необходимо принимать перед приемом пищи. Терапия Макропеном обычно длится от 7 до 10 дней.
У препарата Макропен есть побочные эффекты, к ним относятся:
- снижение аппетита;
- тошнота и рвота;
- аллергические реакции на коже.
А противопоказаниями являются:
- непереносимость препарата;
- печеночная недостаточность в тяжелой форме.
Иммуномодуляторы и витамины
Иммуномодулирующие препараты используются для увеличения устойчивости организма к инфекциям. Они также активизируют работу иммунных клеток, что способствует более быстрому удалению патогенов из организма. Витаминно-минеральные комплексы рекомендуется принимать в течение как минимум месяца для профилактики авитаминоза и ускорения процесса выздоровления.
Одной из наиболее эффективных групп являются препараты, известные как тканевые репаранты. Они способствуют ускорению регенерации поврежденных тканей, а также улучшают кровообращение и питание тканей. Наиболее известным средством из этой категории является Метилурацил.
Уреаплазма-Иммун
Назначаются также иммуномодуляторы, например, Уреаплазма-Иммун. Данный препарат синтезируется из крови людей, затем специальным образом обрабатывается и концентрируется. От применения препарата необходимо отказаться людям, у которых в анамнезе записаны аллергические реакции на белковые препараты, синтезируемые из крови человека.
При необходимости лечение дополняет прием противогрибковых препаратов (Флуконазол, Миконазол), если обнаружено превышение нормы грибков кандида на слизистой половых органов. В мочеиспускательный канал вводятся антисептические растворы, помогающие проводить местную терапию.
Противогрибковые средства
Чтобы избежать появления молочницы у мужчин, используют противогрибковые средства, такие как флуконазол и нистатин.
Народные средства
Народная медицина может дополнять предписания врача. Перед началом самостоятельного лечения следует проконсультироваться с врачом. Широко используются отвары и настойки ягод и листьев брусники, почек березы, семян укропа. Эти целебные растения обладают выраженным уросептическим эффектом, что позволяет использовать их при любых инфекционно-воспалительных заболеваниях урогенитального тракта.
Допустимость использования народных средств при уреаплазмозе
Если у мужчины произошло заражение уреаплазмой, возникает вопрос, что делать в данной ситуации.
Мужчины часто интересуются, возможно ли лечение с помощью народных средств.
Врачи, отвечая на этот вопрос, проявляют осторожность, и это вполне оправдано.
Травы действительно использовались в лечении различных заболеваний задолго до появления доступных медицинских препаратов.
В те времена они могли оказывать определённый эффект, помогая справляться с некоторыми недугами.
Однако в настоящее время ситуация изменилась, как подчеркивают специалисты.
Ранее люди не осознавали, что инфекция может стать хронической и перейти в скрытую форму.
Сегодня эта особенность патогенных микроорганизмов хорошо известна и не должна игнорироваться.
Современные лекарства, особенно антибиотики, при правильном выборе способны уничтожать инфекцию.
В то время как травы, даже если они выбраны правильно, лишь облегчают симптомы.
Но они не могут проникнуть достаточно глубоко в организм, чтобы победить возбудителя болезни.
В результате, пациент, пытаясь вылечиться с помощью трав, рискует ухудшить своё состояние, что часто забывается.
Плюсы физиопроцедурных мероприятий
- Риск развития последствий сводится к нулю;
- Улучшаются обменные процессы организма;
- Повышается иммунитет.
Перечень процедур:
- Массаж влагалища (гинекологический). Позволит избавиться от многих женских инфекций половых органов, нейтрализует развитие спаек и кист;
- Терапия грязью. Устраняет воспаление и другие патологические процессы;
- Для укрепления иммунных сил рекомендуют лечение медицинскими пиявками (гирудотерапию);
- Хороших результатов достигается путём совмещения электрофореза и антибактериальной терапии;
- Какой бы ни выбрали вид процедур, выздоровление будет намного быстрее.
Диета при уреаплазмозе
Список запрещенных к употреблению продуктов был приведен ранее. Рекомендуется включать в рацион натуральные продукты, насыщенные витаминами, такие как овощи и фрукты, а также молочные изделия с низким содержанием жира, йогурты и ацидобифилин.
Хронический уреаплазмоз у мужчин лечение
Длительность терапии 14–21 день. Зависит от наличия уреаплазменного простатита, везикулита или эпидидимита. Наиболее эффективное лечение проводится по следующей схеме:
- Иммуномодулирующая терапия циклофероном, полиоксидонием, пирогеналом и другими иммунными препаратами по специальной для уреаплазменной инфекции методике в течение всего курса лечения. Причем желательно начинать ее за 2–3 дня до начала приема антибиотиков.
- Антибактериальная терапия препаратами из групп макролидов, тетрациклинов, фторхинолонов в течение 14–21 дня. Подбор препарата, рабочая дозировка, комбинация этих лекарств проводится врачом на основании результатов обследования. Это один из самых важных этапов лечения.
- Ферменты типа лонгидазы, лидазы, химотрипсина помогут антибиотику проникнуть в слизистую оболочку, секрет простаты, уменьшат вязкость воспалительной слизи и улучшат ее отток.
- Вспомогательные препараты: простатические, противовоспалительные, уменьшающие отек, спазм протоков простаты, семенных пузырьков подбираются по ситуации.
- Врачебные манипуляции:
- Массаж простаты — очистит протоки железы от скопления слизи, лейкоцитов и уреаплазм, восстановит их проходимость, улучшит кровоток и тонус простаты.
- Физиотерапевтическое лечение начинается при хроническом течении одновременно с иммунной терапией и продолжается весь курс. Оно способствует снятию отека со слизистых оболочек и простаты, улучшению кровоснабжения и доставки антибактериальных и других препаратов непосредственно в пораженные органы и ткани, обладает обезболивающим действием при лечении обострения простатита, эпидидимита. Нами при лечении хронического уреаплазмоза у мужчин используются:
- Магнитно-лазерная терапия по 10 минут 10 сеансов.
- Вибромассаж на простату
- Электрофорез ферментов, антибиотиков ректально на простату и семенные пузырьки или на яичко. 7–10 сеансов по 15 мин.
- Ультразвуковой лазер
Стоимость лечения хронического уреаплазмоза у мужчин зависит от назначенной медикаментозной терапии, от способа введения препаратов и наличия процедур. Если речь идет о поражении только мочеиспускательного канала, то цена лечения в клинике составляет 5–10 тыс. руб. Если же лечится уреаплазменный простатит со всем необходимым комплексом процедур, то лечение может составлять от 15 до 25 тыс. руб., включая препараты.
Соответственно, в зависимости от набора процедур, их количества, типа лекарственных препаратов и способа их введения, складывается общая стоимость.
Вариантов лечения достаточно много, все не описать на сайте. Возможен прием таблеток и прохождение только процедур к клинике. Возможно инъекционное введение лекарств с процедурами.
Конечно же, все виды физиотерапии не назначаются одному и тому же пациенту. Подбираются только те, которые наиболее показаны в данной ситуации.
После лечения хронического уреаплазмоза через 3 недели проводится контрольная диагностика на выявленный вид уреаплазмы и наличие воспаления в уретре и простате. Для этого берут мазок-соскоб, секрет простаты и отправляют в лабораторию для микроскопирования и ПЦР анализа. Иногда добавляют посев. Наиболее правильный ответ дает взятие анализа после медикаментозной провокации.
Кроме поражения мочеполовых органов венерологу приходится лечить у мужчин уреаплазмоз прямой кишки или глотки.
В данных случаях общая терапия проводится по схеме лечения хронического уреаплазмоза, а местные процедуры направлены опять непосредственно в очаг инфекции.
То есть препараты серебра вводятся в виде инстилляций в прямую кишку или орошений глотки, Лазерная терапия, электрофорез применяются также на слизистую ротоглотки и анального канала.
Прежде, чем лечить уреаплазмоз, нужно точно понимать, необходимость его лечения в данный момент, выявить те патологические процессы, которые вызвал этот микроорганизм в мочеполовой системе мужчины и четко разработать индивидуальную схему лечения для конкретного пациента.
Бесконтрольное применение антибиотиков пациентами для домашнего самолечения уреаплазмоза привело к тому, что появилось много штаммов бактерий, нечувствительных к лекарствам.
В ряде случаев вылечить таких больных не представляется возможным из-за полирезистентности уреаплазм к препаратам. Тогда принимается решение наблюдать за изменением количества возбудителя и за воспалительным процессом, который он вызывает в тканях. Такие мужчины 1 раз в 3 месяца сдают количественный анализ ПЦР на уреаплазму, мазок из уретры, сок предстательной железы, посев на уреаплазму. Если ее количество начинает превышать 10*4 степени, а в мазках появляются лейкоциты и слизь, назначается лечение, которое уменьшит число бактерий и уберет их негативное влияние на организм мужчины.
Самым лучшим вариантом лечения уреаплазмоза у мужчин является прохождение терапии под контролем врача венеролога с применением при первом же курсе наиболее эффективной схемы, которая гарантированно уничтожит возбудителя и сохранит здоровье мочеполовой системы пациента.
Рекомендации для домашнего лечения
Уреаплазмоз можно лечить в домашних условиях. Схему медикаментозной терапии можно дополнить методами, которые помогут ускорить восстановление организма:
- Рекомендуется употребление антиоксидантов. Одним из самых простых и доступных вариантов является зеленый чай, который желательно пить по 2-3 чашки в день. Антиоксиданты способствуют укреплению иммунной системы, помогают выводить токсины, уменьшают воспалительные процессы и повышают эффективность лекарств;
- Важно уделять внимание гигиене половых органов. Необходимо ежедневно подмываться, принимать душ, тщательно вытирать гениталии и носить только белье из натуральных тканей. Это поможет поддерживать оптимальную влажность в области наружных половых органов, так как влага создает благоприятные условия для размножения патогенных микроорганизмов. При необходимости врач может назначить мазь с антибактериальными компонентами, что повысит эффективность лечения;
- Следует заботиться о здоровье иммунной системы. В этом помогут не только витаминные комплексы и иммуномодулирующие препараты, но и сбалансированное питание, отказ от вредных привычек, регулярные прогулки и занятия спортом;
- Необходимо бороться с дисбактериозом. Помимо пробиотиков, улучшить микрофлору кишечника могут молочнокислые продукты – кефир, йогурт, творог и сметана. В рационе должно быть много растительной пищи.
Хорошая работа иммунной системы надежно защищает от активации уреаплазмы. Однако это не означает, что мужчины и женщины с отличным здоровьем могут игнорировать лечение.
Защитные силы организма могут ослабнуть в любой момент, что может привести к воспалительным процессам и серьезным заболеваниям.
Всегда ли нужно лечить уреаплазму
Часто на приеме у доктора звучит такой вопрос.
Всегда ли уреаплазмоз должен подвергаться лечению, если анализ на уреаплазму у мужчин дал положительные результаты.
Эта тема до сих пор, как отмечают доктора, остается спорной для многих.
Сегодня врачи ориентируются на то, насколько много микроорганизмов в теле у конкретного пациента.
Ориентирами служат следующие показатели:
- если бактерий не более 10 в третьей степени КОЕмл, то считается, что вызвать воспалительную реакцию в организме они не могут, а значит, необходимость в проведении какого-либо лечения отсутствует
- показатель 10 в 4 степени у мужчин и женщин свидетельствует о том, что стоит проявить настороженность в отношении инфекции, так как вскоре она станет способна спровоцировать воспаление
- если показатель превысил отметку в 10 в 6 степени КОЕмл, говорят о полноценном заболевании, которое требует лечения в ближайшем будущем, если пациент хочет избежать осложнений
Естественно, бывают случаи, требующие индивидуального подхода.
Например, при ВИЧ лечение рекомендуется начинать еще до того, как показатель пересечет критическую отметку.
Связано это со снижением иммунитета, который оказывается не способен справиться даже с минимальной бактериальной нагрузкой на организм.
Контроль эффективности лечения уреаплазмоза
После завершения курса антибиотиков важно вновь посетить врача и пройти контрольные анализы, чтобы удостовериться в эффективности проведенного лечения. Если результаты анализов вновь укажут на наличие инфекции, специалист может назначить другой антибиотик. Обычно такие ситуации возникают по следующим причинам:
- устойчивость штамма к использованному антибиотику,
- ошибки в процессе лечения,
- повторное заражение от полового партнёра.
Критерии выздоровления
После прохождения курса лечения назначается первый контрольный анализ – бактериологический посев. В случае отрицательного результата через месяц необходимо проведение заключительного обследования, чтобы наверняка убедиться в полной излеченности заболевания.
Критериями выздоровления являются следующие факторы:
- Отсутствие каких-либо жалоб со стороны пациента.
- Нормальный внешний вид наружного отверстия уретры.
- Наличие двух отрицательных анализов бактериологического посева.
Лечение уреаплазмоза – длительный и сложный процесс. Часто после прохождения терапии у больных выявляется другой вид уреаплазмы, что требует повторного приема медикаментов. Чтобы вылечить заболевание навсегда, может потребоваться несколько курсов лечения.
Эффективные народные средства
При диагностировании уреаплазмы уреалитикум у мужчин лечение можно проводить не только с помощью традиционных методов. Альтернативная медицина предлагает множество эффективных домашних средств, которые помогут быстро справиться с инфекцией без необходимости обращения к врачу и без вреда для здоровья. Запишите несколько из них, чтобы быть готовыми:
- Настой золотарника. Это простое средство показывает высокую эффективность в борьбе с уреаплазмозом у мужчин. Возьмите 40-50 граммов золотарника и поместите его в небольшую стеклянную емкость, затем добавьте 350 мл кипятка. Оставьте на 35-40 минут в теплом месте. Принимайте по 50 мл четыре раза в день. Курс лечения составляет 20 дней.
- Травяной сбор. Смешайте равные части грушанки, зимолюбки и боровой матки. Общее количество сухой смеси не должно превышать 12 граммов. Залейте травы 500 мл кипятка и прокипятите в течение 5 минут. Затем оставьте в теплом месте. Через 45-50 минут отвар будет готов. Разделите его на 5-6 равных порций и выпейте за один день. Продолжайте лечение в течение 20 дней, и уреаплазмоз отступит.
- Сбор для клизм и наружной гигиены половых органов при уреаплазмозе. Смешайте в металлической емкости корень бадана, боровую матку, курильский чай и кору дуба в соотношении 1:1:1:2. Получившуюся смесь (около 20 граммов) залейте литром кипятка. Поставьте на медленный огонь и варите 15 минут. После этого процедите отвар и дайте настояться не менее 90 минут. Полученного отвара хватит для проведения двух гигиенических процедур.
Факторы, влияющие на эффективность лечения
Использование антибиотиков даже с самым высоким терапевтическим эффектом не гарантирует полное уничтожение инфекции, если в период лечения не соблюдаются следующие правила:
- Пациент должен строго соблюдать все предложенные врачом рекомендации. Препараты можно принимать по инструкции, но часто урологи подбирают индивидуальные дозировки, кратность и приема и общую продолжительность курса. Все это нужно учитывать в период терапии;
- Курс приема антибиотиков и других лекарственных средств прерван. Зачастую, особенно это касается мужчин, антибиотики пьются первые несколько дней, затем их прием прекращается. Это приводит к исчезновению симптомов уреаплазмы, но полностью возбудителя инфекции не уничтожает, то есть создаются предпосылки для перехода заболевания в хроническую форму;
- Необходимо, чтобы половой партнер также пролечился. Если этого не сделать, то повторное инфицирование возможно в любой момент.
Самостоятельно лекарства подбирать нельзя, так как это часто приводит к возникновению нежелательных осложнений, лечение которых может потребовать много терпения и финансовых вложений.
После курса антибактериального лечения необходимо повторное проведение анализов. Но сразу его не делают, так как в биоматериале могут некоторое время сохраняться антитела. Обычно врачи рекомендуют анализы сдать через месяц после завершения курса.
Требуется ли лечение партнера
Нужно ли что-то принимать по окончании лечения уреаплазмы?
Очень эффективно дополнять терапию местным и физиотерапевтическими методами. После антибиотикотерапии рекомендуется для профилактики нормализовать микрофлору кишечника. Препараты выбора, это: Бифиформ и Линекс.
Для повышения иммунитета, пациентам назначают комплексы поливитаминов, например, Витрум, Биомакси и другие.
Из естественных иммуномодуляторов назначаются препараты на основе лекарственных трав: лимонник, отвар шиповника, эхинацея и др.
Также лучше назначить щадящую диету. Рацион питания исключает острое, пересоленое, высокие концентрации жира и жаренное, алкоголь.
После окончания лечения уреаплазмоза, мужчине следует повторно обследоваться у врача. Профилактическую терапию также должны пройти половые партнеры мужчины, у которого диагностировали уреаплазму.
Рецидив или повторное заражение у мужчин
Если симптомы возвращаются, обязательно стоит снова обратиться к врачу.
Важно: Ни в коем случае не следует самостоятельно назначать себе повторный курс лечения теми же препаратами, которые были прописаны врачом ранее!
Чаще всего, если уреаплазма не была полностью вылечена, она может развить устойчивость к использованным медикаментам. Такие действия могут привести к тому, что инфекция перейдет в хроническую и труднолечимую форму. Кроме того, симптомы уреаплазмоза очень похожи на проявления, вызванные другими микроорганизмами, такими как гарднерелла. Если вы обращаетесь к платному специалисту, который не знаком с вашей медицинской историей, обязательно расскажите о предыдущем случае и о том, какие препараты использовались и по какой схеме проводилось лечение. Убедитесь, что курс лечения был завершен полностью и были ли сданы контрольные анализы.
Возможные последствия и осложнения
Уреаплазмоз у мужчин при отсутствии соответствующей терапии способен приводить к развитию серьезных осложнений. Ферменты, синтезируемые Ureaplasma urealyticum в процессе жизнедеятельности, способны изменять вязкость спермы, а также растворять оболочку сперматозоидов. Помимо этого, хронический воспалительный процесс в тканях яичка и его придатков вызывает нарушения сперматогенеза, т. е. процесса образования и созревания сперматозоидов. Все это в конечном итоге приводит к формированию бесплодия.
Другим осложнением уреаплазмоза у мужчин может стать развитие стриктуры уретры (сужения мочеиспускательного канала), приводящей к затруднению мочеиспускания вплоть до острой задержки мочи.
Осложнение уреаплазмоза – болезнь Рейтера
Уреаплазмы могут быть одной из причин возникновения болезни Рейтера.
Это заболевание характеризуется множественными симптомами.
Оно затрагивает суставы, урогенитальную систему, глаза и кожу.
Мужчины страдают от этой болезни как минимум в 20 раз чаще, чем женщины.
Некоторые исследования указывают на соотношение 1 к 100.
Долгосрочное носительство уреаплазм может инициировать реактивные процессы.
В результате возникают аутоиммунные реакции.
Это воспалительные процессы, при которых иммунная система начинает атаковать собственные ткани организма.
Вероятность развития болезни Рейтера значительно возрастает у мужчин, у которых уреаплазмы попадают в предстательную железу.
У пациентов с хроническим простатитом заболевание протекает тяжело и с частыми рецидивами.
Существует две стадии болезни Рейтера.
Первая стадия – инфекционно-токсическая.
В этой стадии формируется очаг воспаления в урогенитальном тракте.
Он становится источником токсемии и аутосенсибилизации организма.
На этом этапе могут появляться боли в суставах.
Однако этиотропное лечение с высокой вероятностью приведет к устранению всех симптомов.
Если пациент не получает необходимую терапию, что происходит довольно часто, то через 2-3 месяца наступает вторая стадия.
Мужчины, как правило, не обращаются за лечением, поскольку у них отсутствуют ярко выраженные клинические проявления.
Вторая стадия – аутоиммунная.
На этой стадии возникают стойкие и рецидивирующие очаги аутоиммунного воспаления в различных частях тела.
Воспаляются суставы, глаза и уретра.
Диагностика становится сложной, так как пациенты с воспалением суставов обращаются к ревматологу, который не всегда рассматривает болезнь Рейтера как возможную причину.
Признаки уретрита часто связываются с инфекциями урогенитального тракта.
Хотя воспаление уже вызвано реактивными процессами.
Оно может стать хроническим и продолжаться месяцами.
Суставы начинают болеть в среднем через месяц после появления симптомов воспаления мочеиспускательного канала.
Заболевание затрагивает крупные и нагруженные суставы.
Чаще всего это суставы нижних конечностей.
Болезнь проявляется в виде полиартрита.
Кожа над суставами может быть горячей на ощупь.
Покраснение обычно отсутствует, оно наблюдается только при вовлечении мелких суставов.
Может возникать значительный выпот.
Наибольшую опасность представляет поражение сердечно-сосудистой системы.
Возможны такие осложнения, как аортит, миокардит и развитие сердечных пороков.
Другие осложнения уреаплазмоза у мужчин
Уреаплазмоз у мужчин часто приводит к инфицированию простаты.
Иногда поражаются яички с придатками.
При уреаплазменном простатите симптомов обычно нет.
Либо они появляются, но выражены очень слабо.
Мужчина жалуются на дискомфорт в тазовой области.
Может нарушаться половая функция.
Отмечаются затруднения при мочеиспускании.
Главная же опасность уреаплазмоза при распространении на простату состоит в том, что эта инфекция является предрасполагающим фактором для присоединения вторичной бактериальной флоры.
Могут возникать острые простатиты.
Возможен небольшой отек.
При пальпации отмечается умеренная болезненность и инфильтрация придатка яичка.
В редких случаях уреаплазмоз приводит к мужскому бесплодию.
Снижение качества спермы обусловлено воспалением простаты или яичек.
Меры предосторожности и профилактика заболевания
Чтобы избежать развития патологий мочеполовой системы, следуйте следующим рекомендациям:
- Применяйте барьерные методы контрацепции. Они не только защитят от уреаплазмоза, но и помогут предотвратить серьезные и неизлечимые заболевания, такие как ВИЧ;
- Родители должны проводить профилактические беседы с подростками. В настоящее время среди молодежи наблюдается рост венерических и половых инфекций, включая уреаплазмоз;
- Регулярно проходите обследование, как минимум раз в год. Мужчинам следует посещать уролога, а женщинам – гинеколога. Если у одного из партнеров выявлена болезнь, лечение должно быть совместным;
- Стрессы, депрессии и переохлаждения могут ослабить иммунную систему. Старайтесь избегать этих негативных факторов;
- В межсезонье рекомендуется принимать поливитамины;
- Соблюдайте сбалансированное и правильное питание;
- Не занимайтесь самолечением и не принимайте лекарства без назначения врача;
- Используйте антисептики после незащищенного полового акта, но не позднее чем через 3 часа;
- Если у вас обнаружено венерическое заболевание, рекомендуется пройти тестирование на другие скрытые инфекции.
Что делать если у партнёрши есть уреаплазмоз, а у мужчины нет
Часто бывает так, что оба партнера обращаются для обследования вместе.
Например, они готовятся к беременности.
Или кто-то из партнеров обнаружил у себя подозрительные симптомы, указывающие на воспаление уретры.
По итогам обследования бывает так, что инфекция выявляется только у женщины.
В таком случае она должна получить лечение.
А мужчина должен получить медикаментозную профилактику.
Она проводится колларголом, которым промывают уретру.
Внутрь принимается однократно доза антибиотика.
Половые контакты запрещены на весь период лечения.
После завершения терапии сексом можно заниматься в презервативе вплоть до подтверждения излеченности.
Вывод
Уреаплазмоз является инфекцией, которая передается через половые контакты. Чтобы предотвратить развитие этого заболевания, важно избегать случайных незащищенных сексуальных отношений и поддерживать иммунную систему в хорошем состоянии.
Психологические аспекты уреаплазмоза у мужчин
Уреаплазмоз, как и многие другие заболевания, может оказывать значительное влияние на психологическое состояние мужчин. Понимание этих аспектов важно для комплексного подхода к лечению и реабилитации пациентов. Уреаплазма, являясь условно-патогенной бактерией, может вызывать не только физические симптомы, но и эмоциональные и психологические проблемы.
Одним из наиболее распространенных психологических последствий уреаплазмоза является чувство стыда и вины. Мужчины, столкнувшиеся с этой инфекцией, могут испытывать страх перед осуждением со стороны партнеров или общества. Это может привести к снижению самооценки и развитию комплексов, связанных с сексуальной функцией и здоровьем. Страх перед возможными осложнениями, такими как бесплодие или хронические заболевания, также может усиливать тревожность и депрессию.
Кроме того, уреаплазмоз может вызывать проблемы в интимных отношениях. Мужчины могут избегать близости из-за страха передачи инфекции партнеру или из-за физического дискомфорта, связанного с симптомами заболевания. Это может привести к ухудшению отношений, возникновению недопонимания и конфликтов с партнером, что, в свою очередь, усугубляет психологическое состояние пациента.
Важно отметить, что мужчины могут испытывать и другие эмоциональные реакции, такие как гнев, раздражительность или апатию. Эти состояния могут быть вызваны не только физическими симптомами, но и общим стрессом, связанным с заболеванием. Негативные эмоции могут повлиять на качество жизни, работу и социальные взаимодействия, что требует внимания со стороны специалистов.
Для преодоления психологических аспектов уреаплазмоза важно обращаться за помощью к психологам или психотерапевтам. Профессиональная поддержка может помочь мужчине справиться с негативными эмоциями, повысить самооценку и восстановить уверенность в себе. Также полезно открыто обсуждать свои переживания с партнером, что может способствовать укреплению отношений и снижению уровня тревожности.
В заключение, уреаплазмоз у мужчин — это не только медицинская проблема, но и серьезный вызов для психоэмоционального состояния. Комплексный подход к лечению, включающий как медицинские, так и психологические аспекты, является ключом к успешному восстановлению и улучшению качества жизни пациента.
Вопрос-ответ
Как понять, что у мужчины уреаплазмоз?
Симптомы уреаплазмоза: боль или чувство жжения при мочеиспускании. Чувство неопределенного дискомфорта в области мошонки или промежности. Чувство переполнения мочевого пузыря, облегчение не наступает даже после мочеиспускания. Частые позывы к мочеиспусканию.
Какое эффективное лечение уреаплазмы у мужчин?
Для лечения уреаплазмоза врач назначает антибиотики. Это могут быть препараты группы тетрациклина (доксициклин), макролидов (азитромицин, джозамицин), фторхинолонов (ципролет, ципрофлоксацин). Препараты назначаются перорально в таблетках. Курс антибиотиков составляет 7-10 дней.
Где болит при уреаплазме?
Симптомы уреаплазмоза: дискомфорт при мочеиспускании (жжение или рези), болезненность полового контакта, более частое мочеиспускание, боли в нижней части живота (в области расположения репродуктивных органов).
Какой препарат убивает уреаплазму?
Для лечения уреаплазмоза обычно применяются антибиотики, такие как доксициклин, азитромицин и моксифлоксацин. Выбор препарата зависит от конкретной ситуации и чувствительности микроорганизмов, поэтому важно обратиться к врачу для назначения адекватной терапии.
Советы
СОВЕТ №1
Регулярно проходите медицинские обследования. Уреаплазма может не проявляться яркими симптомами, поэтому важно регулярно проверяться у врача, особенно если у вас есть рискованные факторы или вы замечаете изменения в здоровье.
СОВЕТ №2
Обратите внимание на симптомы. Если вы заметили дискомфорт при мочеиспускании, выделения из половых органов или другие необычные симптомы, не откладывайте визит к врачу. Раннее выявление инфекции поможет избежать осложнений.
СОВЕТ №3
Следуйте рекомендациям врача по лечению. Если у вас диагностирована уреаплазма, строго придерживайтесь назначенного курса антибиотиков и не прерывайте лечение, даже если симптомы исчезли. Это поможет предотвратить рецидивы и развитие устойчивости к лекарствам.
СОВЕТ №4
Обсуждайте вопросы сексуального здоровья с партнером. Открытое общение о здоровье и возможных рисках поможет вам и вашему партнеру принимать обоснованные решения и снизить вероятность передачи инфекции.